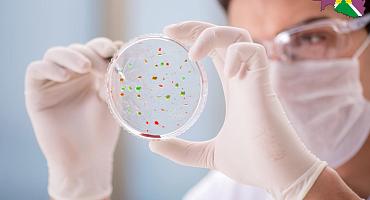
Профилактика острых кишечных инфекций

-
Район
- Новости и анонсы событий
- Общая информация
- История
- Символика
- Город Усть-Лабинск
- Сельские поселения
- Совет района
- Контрольно-счетная палата
- Территориальная избирательная комиссия
- Правоохранительные органы
- Инвестиционная привлекательность
- СМИ
- Целевые программы
- Сельское хозяйство
- Организации ЖКХ
- Стандарт развития конкуренции
- Публичные слушания
- Антимонопольный комплаенс
- Общественная палата
- Календарь обязанностей проверяемых лиц
- Официальное опубликование
- Служба по контракту: условия и меры поддержки
-
Администрация
- Глава муниципального образования Усть-Лабинский район
- Руководители
- Структура администрации района
- Полномочия, задачи и функции
- Управления и отделы
- Кадровое обеспечение
- Резерв управленческих кадров
- Подведомственные организации
- Официальные заявления и отчеты
- Обращения граждан
- Предоставление муниципальных услуг
- Территориальные органы и представительства
- Защита населения при возникновении ЧС
- Участие в программах и международное сотрудничество
- Фонды и некоммерческие организации
- Открытые данные
- Росреестр
- Гражданское общество и НКО
-
Противодействие коррупции
- Нормативно-правовые и иные акты в сфере противодействия коррупции
- Антикоррупционная экспертиза
- Антикоррупционное правовое просвещение
- Методические материалы
- Формы документов, связанных с противодействием коррупции, для заполнения
- Сведения о доходах, расходах, об имуществе и обязательствах имущественного характера
- Комиссия по соблюдению требований к служебному поведению и урегулированию конфликта интересов (аттестационная комиссия)
- Сообщить о факте коррупции
-
Град. деятельность
- Информация о сфере градостроительства
- Информация об органах МСУ, предоставляющих услуги в сфере градостроительства и строительства
- Информация о порядке получения информации о градостроительных условиях
- Документы территориального планирования
- Исчерпывающие перечни процедур в сфере строительства
- Документация по планировке территорий
- Приобрести земельный участок
- Получить услугу в сфере строительства
- График обучающих семинаров для участников градостроительной деятельности
- Экспертиза инженерных изысканий и проектной документации
- Получить сведения из информационных систем в сфере градостроительной деятельности
- Статистическая информация и иные сведения о градостроительной деятельности
- Правила землепользования и застройки
- Калькулятор процедур
- Предоставление разрешений на условно разрешенный вид
- Полезные ссылки
- Общие документы
- Памятка инвестору о регистрации прав собственности
- Комплексное развитие территории (КРТ)
- Отклонения от предельных параметров разрешенного строительства
-
Информация для жителей
- Бесплатная юридическая помощь
- Здравоохранение
- Социальная сфера
- Социальная защита
- Краевое БТИ
- Приём граждан
- Коммунальные услуги
- Органы и учреждения системы профилактики
- О предоставлении земельных участков
- О кадастровой стоимости
- ГИС ЖКХ
- ДОГАЗИФИКАЦИЯ
- ЗАГОТОВКА ДРОВ
- Гражданам, прибывающим с территории Украины, ДНР и ЛНР
- ВЫЯВЛЕНИЕ ПРАВООБЛАДАТЕЛЕЙ РАНЕЕ УЧТЕННЫХ ОБЪЕКТОВ НЕДВИЖИМОСТИ
- Транспортная безопасность
- Проведение комплексных кадастровых работ
- Правила информационной безопасности при работе в информационно-телекоммуникационной сети "Интернет"
- Изменен порядок исчисления средней заработной платы
- Вакансии
- Контакты